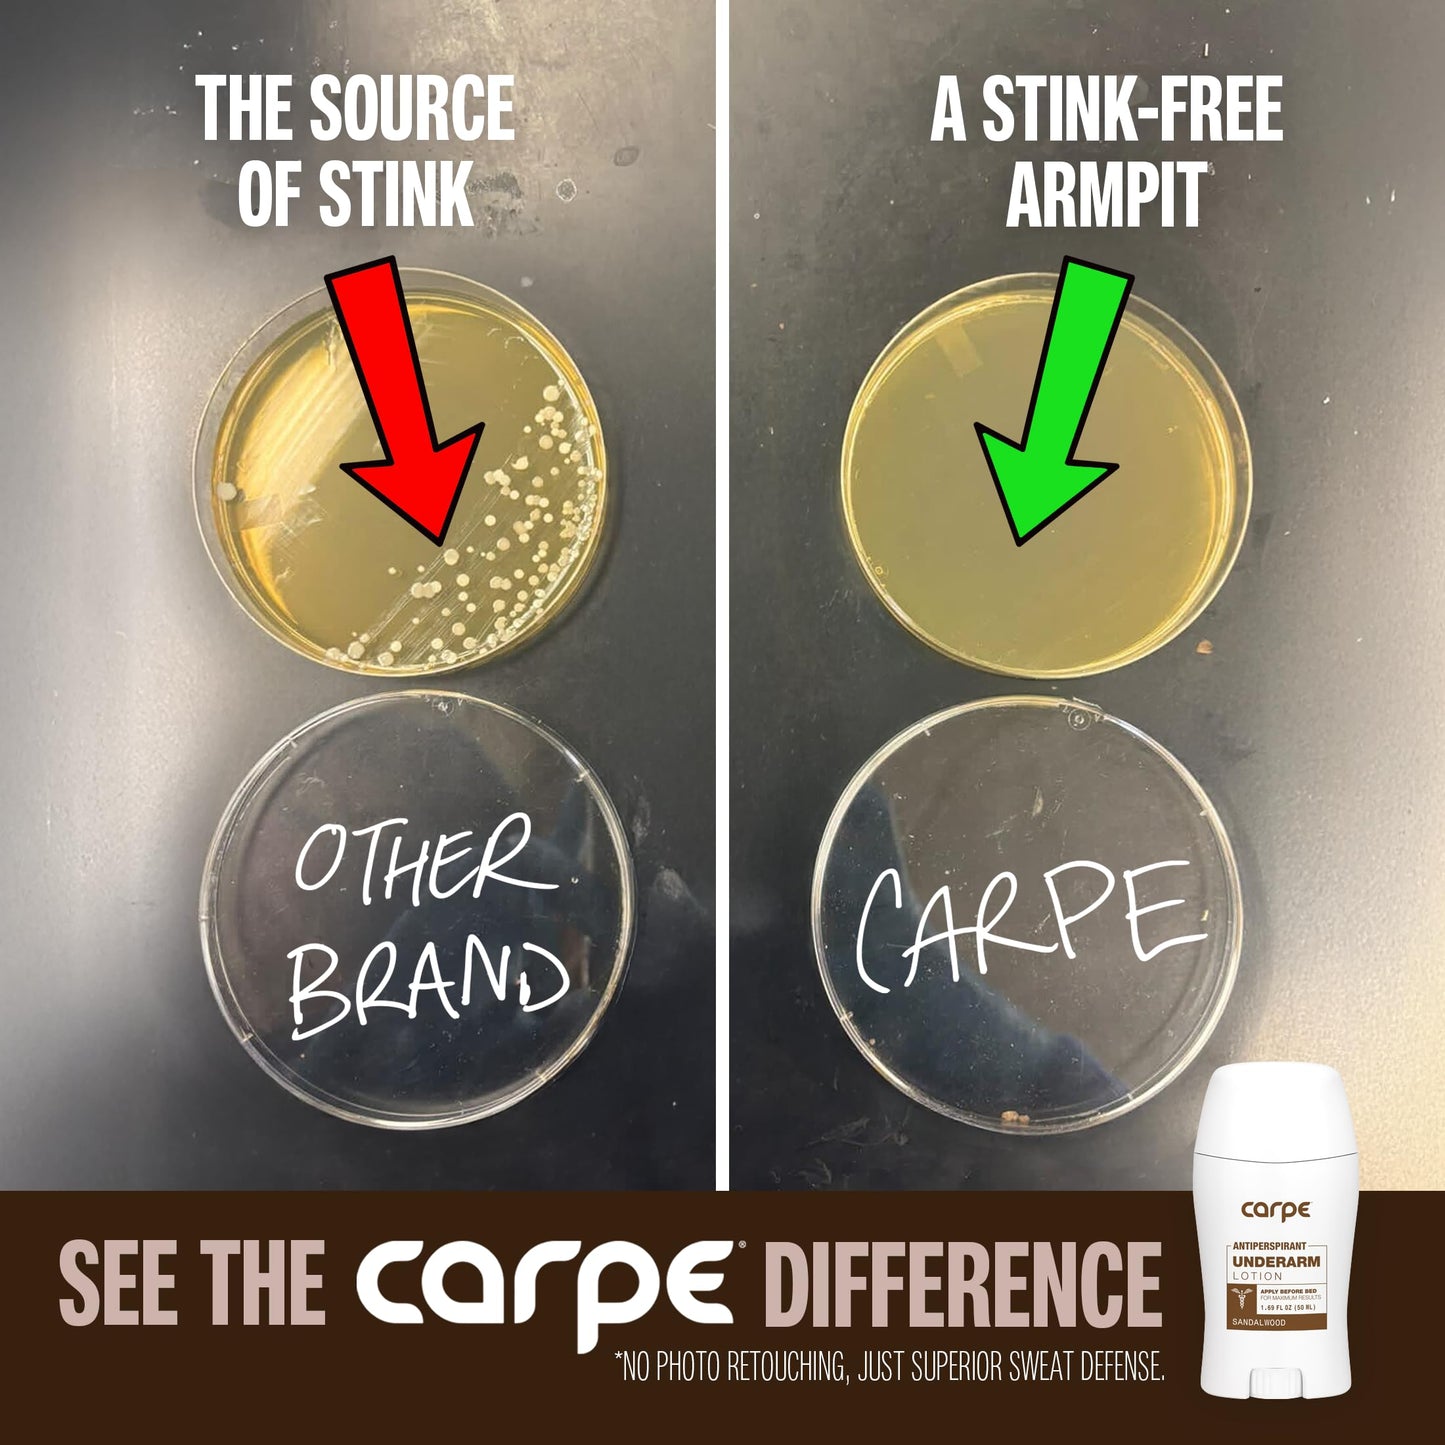

1
/
of
9
Carpe
Carpe Clinical Strength Underarm Antiperspirant and Deodorant, Sandalwood Scent
Carpe Clinical Strength Underarm Antiperspirant and Deodorant, Sandalwood Scent
Regular price
$25.49 USD
Regular price
$50.99 USD
Sale price
$25.49 USD
Shipping calculated at checkout.
Quantity
Couldn't load pickup availability
Features:
- EFFICACY OPTIMIZED: The dermatologist-recommended clinical strength solution for excessive sweating. Our antiperspirant and deodorant was specifically designed to stop underarm sweat and help manage the symptoms of hyperhidrosis. Work toward zero sweat, restore confidence, and enjoy life with dry and fresh underarms!
- EASY TO USE: With a thin layer of Carpe Antiperspirant Lotion you can reduce sweat with safe and effective ingredients. Apply before bed for best results and say goodbye to your sweaty, smelly underarms without the downsides of prescription oral treatments or iontophoresis
- AS SEEN ON GOOD MORNING AMERICA: A smooth, non-greasy antiperspirant lotion made for the sweatiest underarms, Carpe includes natural eucalyptus oil and moisturizing ingredients that gently soothe the skin, and avoids greasiness with its quick-drying properties
- DEVELOPED WITH DERMATOLOGISTS: Carpe’s scientifically developed formula has been independently tested for safety and efficacy, and proven to be a leading over-the-counter sweat treatment.
- DON’T SWEAT IT: Full Money Back Guarantee. Packaging may vary, Box may not be included. Free from Parabens, Phthalates, Formaldehydes, and Sulfates - Never tested on animals - Filled in the USA
- DIRECTIONS- PLEASE READ: Apply every night before bed and again every morning. For maximum efficacy and best results, use consistently for 4 weeks. Consistency is key. Applying before bed is very important to achieving great results because you're sweating less at night, which allows the product to have the most effect.
Package Dimensions: 4.5 x 2.1 x 1.1 inches
Share